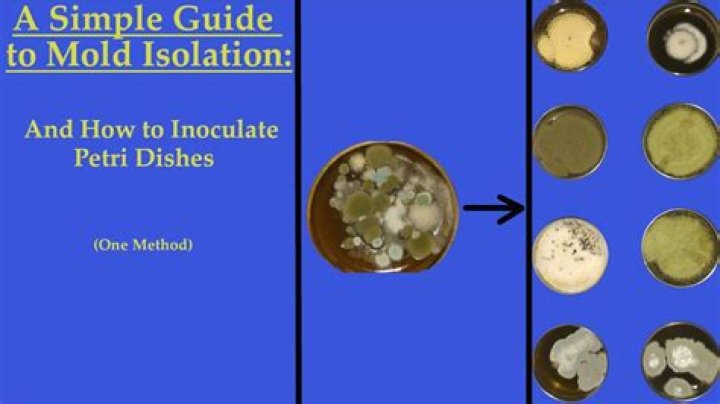

Should petri dish be capitalized?
 Ava Wright
Ava Wright
Capitalization. Petri should contain a capital P. If you read scientific texts it will usually be capitalised. Search Pubmed or something for an article containing Petri dishes for examples, it's pretty much universally capital P.
How do you use petri dish in a sentence?
It usually happens on the midnight tour, the petri dish of police misbehavior. I'm trying to grow bacteria with unflavored gelatin in petri dishes. The endless buses of news media were its principal petri dish. It's like other businesses, but in an accelerated petri dish ."
How do you spell Petri as in petri dish?
A Petri dish (alternatively known as a Petri plate or cell-culture dish) is a shallow transparent lidded dish that biologists use to hold growth medium in which cells can be cultured, originally, cells of bacteria, fungi and small mosses.
What do you mean by petri dish?
1 : a small shallow dish of thin glass or plastic with a loose cover used especially for cultures in bacteriology. 2 : something (such as a place or situation) that fosters development or innovation the college was a petri dish for radical views.
Why does a petri dish have a lid?
Reason - The lid stops additional unwanted bacteria in the air contaminating the plate. ... Labels are important, as this identifies the growing bacterium. If the lid is separated from the petri dish for some reason, the label will stay with the part that has the bacteria on it, so it can be identified.
Bacterial Isolation on Petri Dish - Biology Lab Techniques
34 related questions foundAre petri dishes airtight?
No, our petri dishes are not air tight. ... Most petri dishes are going to be loose so that the germs inside, when applied, can breathe and survive. Most experiments require you to tape the two lids together but that might not be something that works for you.
What is a petri dish and cover used for?
a shallow, circular, glass or plastic dish with a loose-fitting cover over the top and sides, used for culturing bacteria and other microorganisms.
Is petri dish a proper noun?
Capitalization. Petri should contain a capital P. If you read scientific texts it will usually be capitalised. Search Pubmed or something for an article containing Petri dishes for examples, it's pretty much universally capital P.
What is a petri dish for kids?
A petri dish is a small dish shaped like a cylinder. Scientists use it to grow cells from animals, fungus, and diseases so they can study them. They are usually made of glass or plastic. The glass ones can be used again if they are heated at 160°F.
Is a petri dish living or nonliving?
We have concluded that these objects are not living because they did not respond to the stimuli of the penny being dropped in the petri dish. Each time we tested the objects, they achieved a five, meaning they did not change at all.
Why are petri dishes upside down?
Petri dishes need to be incubated upside-down to lessen contamination risks from airborne particles landing on them and to prevent the accumulation of water condensation that could disturb or compromise a culture.
What is the gel in a petri dish?
Agar is a natural gelling agent derived from marine algae. It is resistant to consumption by bacteria, making it ideal as a medium on which to grow bacteria cultures in petri dishes. It is available in several raw forms including tablets and liquid, but preparing agar powder for use in petri dishes is straightforward.
How do you make agar petri dishes?
Mix 1 level teaspoon of dehydrated agar with 100 ml (3/8 cup) of room-temperature water. Bring to a boil while stirring to ensure the agar is completely dissolved. Pour 10-12 ml of hot agar into each petri dish, just covering the bottom. Replace the dish top immediately after pouring to prevent contamination.
How is agar used?
Agar can be used as a laxative, an appetite suppressant, a vegetarian substitute for gelatin, a thickener for soups, in fruit preserves, ice cream, and other desserts, as a clarifying agent in brewing, and for sizing paper and fabrics.
How do you swab for germs?
Roll a clean cotton swab in your mouth and then lightly draw a squiggle over the gelled agar in the petri dish. Be sure to wipe the end of the cotton swab all over the surface to be tested and cover the entire end of the swab with invisible bacteria.
Can you grow bacteria without agar?
Plain agar won't work because it contains no 'food' for the bacteria. You have to buy NUTRIENT agar because that has sugars, salts, nitrogen source, etc that bacteria need to grow.
How do you identify bacteria in a petri dish?
Bacteria. Each distinct circular colony should represent an individual bacterial cell or group that has divided repeatedly. Being kept in one place, the resulting cells have accumulated to form a visible patch. Most bacterial colonies appear white, cream, or yellow in color, and fairly circular in shape.
What is a petri dish used for in lab?
What is it? A Petri dish is a shallow transparent glass or plastic cylindrical lidded dish, used to contain a thin layer of agar on which to grow bacteria and fungi. Millions of Petri dishes are used in microbiology labs every year.
What would a petri dish be best used for in a science laboratory?
Petri dish is majorly used as laboratory equipment in the field of biology & chemistry. The dish is used to culture cells by providing storage space and preventing them from getting contaminated. Since the dish is transparent, it is easy to observe the growth stages of microorganisms clearly.
What is a petri dish used for in biology?
The name comes from a German bacteriologist, J. R. Petri. Petri dishes are used in the laboratory primarily for cell cultures. An agar is usually used as a culture medium for growing cells, such as microbial cells. The transparent feature of the dish is essential for observing the contents without lifting the cover.
How do you seal a glass petri dish?
Just buy a cling wrap from any convenience store, cut them up to small sizes desired and used them to seal your bottles, petri dishes. It's cheap and most importantly, it does not contaminate your specimens/samples at all! Plastic tape for grafting is sufficient if you don't mind air ventulation.
Is agar agar used for petri dishes?
A Petri dish (Petri plate) is a shallow cylindrical glass lidded dish that is typically used to culture microorganisms (agar plates). ... Although it has other uses including culinary and dentistry, agar plays an important role in microbiology as culture media for a variety of microorganisms.
What happens if agar is too hot?
If the agar is too hot, the bacteria in the sample may be killed. If the agar is too cool, the medium may be lumpy once solidified.



